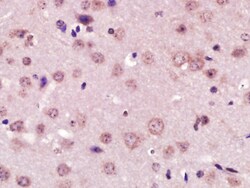

Antibody data
- Antibody Data
- Antigen structure
- References [0]
- Comments [0]
- Validations
- Immunohistochemistry [4]
Submit
Validation data
Reference
Comment
Report error
- Product number
- BS-6634R - Provider product page

- Provider
- Invitrogen Antibodies
- Product name
- XPC Polyclonal Antibody
- Antibody type
- Polyclonal
- Antigen
- Synthetic peptide
- Reactivity
- Human, Mouse, Rat
- Host
- Rabbit
- Isotype
- IgG
- Vial size
- 100 µL
- Concentration
- 1 mg/mL
- Storage
- -20°C
No comments: Submit comment
Supportive validation
- Submitted by
- Invitrogen Antibodies (provider)
- Main image

- Experimental details
- Formalin-fixed and paraffin embedded human gastric cancer labeled with Anti-XPC Polyclonal Antibody, Unconjugated (bs-6468R) at 1:200 followed by conjugation to the secondary antibody.
- Submitted by
- Invitrogen Antibodies (provider)
- Main image

- Experimental details
- Paraformaldehyde-fixed, paraffin embedded rat brain tissue; Antigen retrieval by boiling in sodium citrate buffer(pH6) for 15min; Block endogenous peroxidase by 3% hydrogen peroxide for 30 minutes; Blocking buffer (normal goat serum) at 37°C for 20min; Antibody incubation with Rabbit Anti-XPC Polyclonal Antibody, Unconjugated (bs-6634R) at 1:200 overnight at 4°C, followed by a conjugated secondary and DAB staining.
- Submitted by
- Invitrogen Antibodies (provider)
- Main image

- Experimental details
- Paraformaldehyde-fixed, paraffin embedded rat brain tissue; Antigen retrieval by boiling in sodium citrate buffer(pH6) for 15min; Block endogenous peroxidase by 3% hydrogen peroxide for 30 minutes; Blocking buffer (normal goat serum) at 37°C for 20min; Antibody incubation with Rabbit Anti-XPC Polyclonal Antibody, Unconjugated (bs-6634R) at 1:200 overnight at 4°C, followed by a conjugated secondary and DAPI staining.
- Submitted by
- Invitrogen Antibodies (provider)
- Main image
- Experimental details
- Paraformaldehyde-fixed, paraffin embedded mouse brain; Antigen retrieval by boiling in sodium citrate buffer (pH6) for 15min; Block endogenous peroxidase by 3% hydrogen peroxide for 30 minutes; Blocking buffer (normal goat serum) at 37°C for 20min; Antibody incubation with XPC Polyclonal Antibody (bs-6634R) at 1:400 overnight at 4°C, followed by a conjugated secondary and DAB staining.